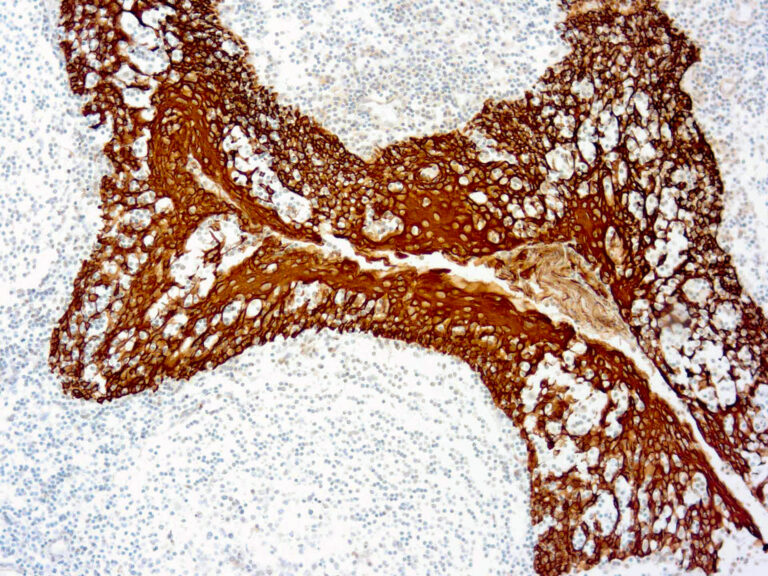

Human Disabled homolog 2 ELISA Kit
ORB1659102
ReactivityHuman
Product group Assays
Overview
- SupplierBiorbyt
- Product NameHuman Disabled homolog 2 ELISA Kit
- Delivery Days Customer10
- Application Supplier NoteDetect Range: 0.156-10 ng/mL. Sensitivity: less than 0.078 ng/mL. Assay Time: 3-5 h. Detection wavelength: 450 nm. Sample Volume: 100 microL. Sample Type: Serum, plasma, tissue homogenates and other biological fluids.
- ApplicationsELISA
- Applications SupplierELISA
- CertificationResearch Use Only
- Scientific DescriptionHuman Disabled homolog 2 ELISA Kit
- ReactivityHuman
- UNSPSC41116158